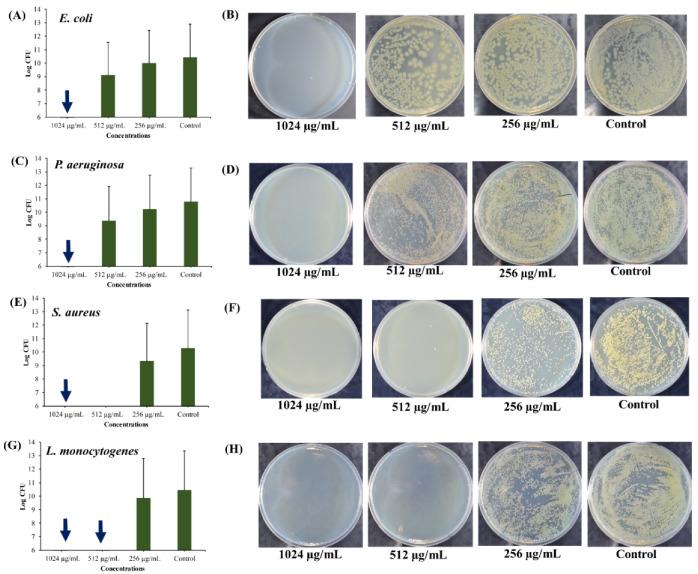
https://cdn.ncbi.nlm.nih.gov/pmc/blobs/362c/7281555/ead6de336613/marinedrugs-18-00270-g006.jpg

岩白菜素壳聚糖纳米粒子对生物膜形成病原菌的持留细胞的杀菌活性。
Bactericidal Activity of Usnic Acid-Chitosan Nanoparticles against Persister Cells of Biofilm-Forming Pathogenic Bacteria.
机构信息
Institute of Food Science, Pukyong National University, Busan 48513, Korea.
Food Safety and Processing Research Division, National Institute of Fisheries Science, Busan 46083, Korea.
出版信息
Mar Drugs. 2020 May 20;18(5):270. doi: 10.3390/md18050270.
The present study aimed to prepare usnic acid (UA)-loaded chitosan (CS) nanoparticles (UA-CS NPs) and evaluate its antibacterial activity against biofilm-forming pathogenic bacteria. UA-CS NPs were prepared through simple ionic gelification of UA with CS, and further characterized using Fourier transform infrared spectroscopy, X-ray diffraction, and field-emission transmission electron microscopy. The UA-CS NPs presented a loading capacity (LC) of 5.2%, encapsulation efficiency (EE) of 24%, and a spherical shape and rough surface. The maximum release of UA was higher in pH 1.2 buffer solution as compared to that in pH 6.8 and 7.4 buffer solution. The average size and zeta potential of the UA-CS NPs was 311.5 ± 49.9 nm in diameter and +27.3 ± 0.8 mV, respectively. The newly prepared UA-CS NPs exhibited antibacterial activity against persister cells obtained from the stationary phase in batch culture, mature biofilms, and antibiotic-induced gram-positive and gram-negative pathogenic bacteria. Exposure of sub-inhibitory concentrations of UA-CS NPs to the bacterial cells resulted in a change in morphology. The present study suggests an alternative method for the application of UA into nanoparticles. Furthermore, the anti-persister activity of UA-CS NPs may be another possible strategy for the treatment of infections caused by biofilm-forming pathogenic bacteria.
本研究旨在制备载乌头酸(UA)的壳聚糖(CS)纳米颗粒(UA-CS NPs),并评价其对生物膜形成致病菌的抗菌活性。UA-CS NPs 通过 UA 与 CS 的简单离子凝胶化制备,并通过傅里叶变换红外光谱、X 射线衍射和场发射透射电子显微镜进行进一步表征。UA-CS NPs 的载药量(LC)为 5.2%,包封效率(EE)为 24%,呈球形且表面粗糙。与 pH 6.8 和 7.4 缓冲溶液相比,UA-CS NPs 在 pH 1.2 缓冲溶液中的最大释放量更高。UA-CS NPs 的平均粒径和 zeta 电位分别为 311.5±49.9nm 和+27.3±0.8mV。新制备的 UA-CS NPs 对分批培养中静止期获得的持久细胞、成熟生物膜以及抗生素诱导的革兰氏阳性和革兰氏阴性致病菌均表现出抗菌活性。亚抑制浓度的 UA-CS NPs 暴露于细菌细胞会导致形态发生变化。本研究为将 UA 应用于纳米颗粒提供了一种替代方法。此外,UA-CS NPs 的抗持久活性可能是治疗生物膜形成致病菌感染的另一种可能策略。